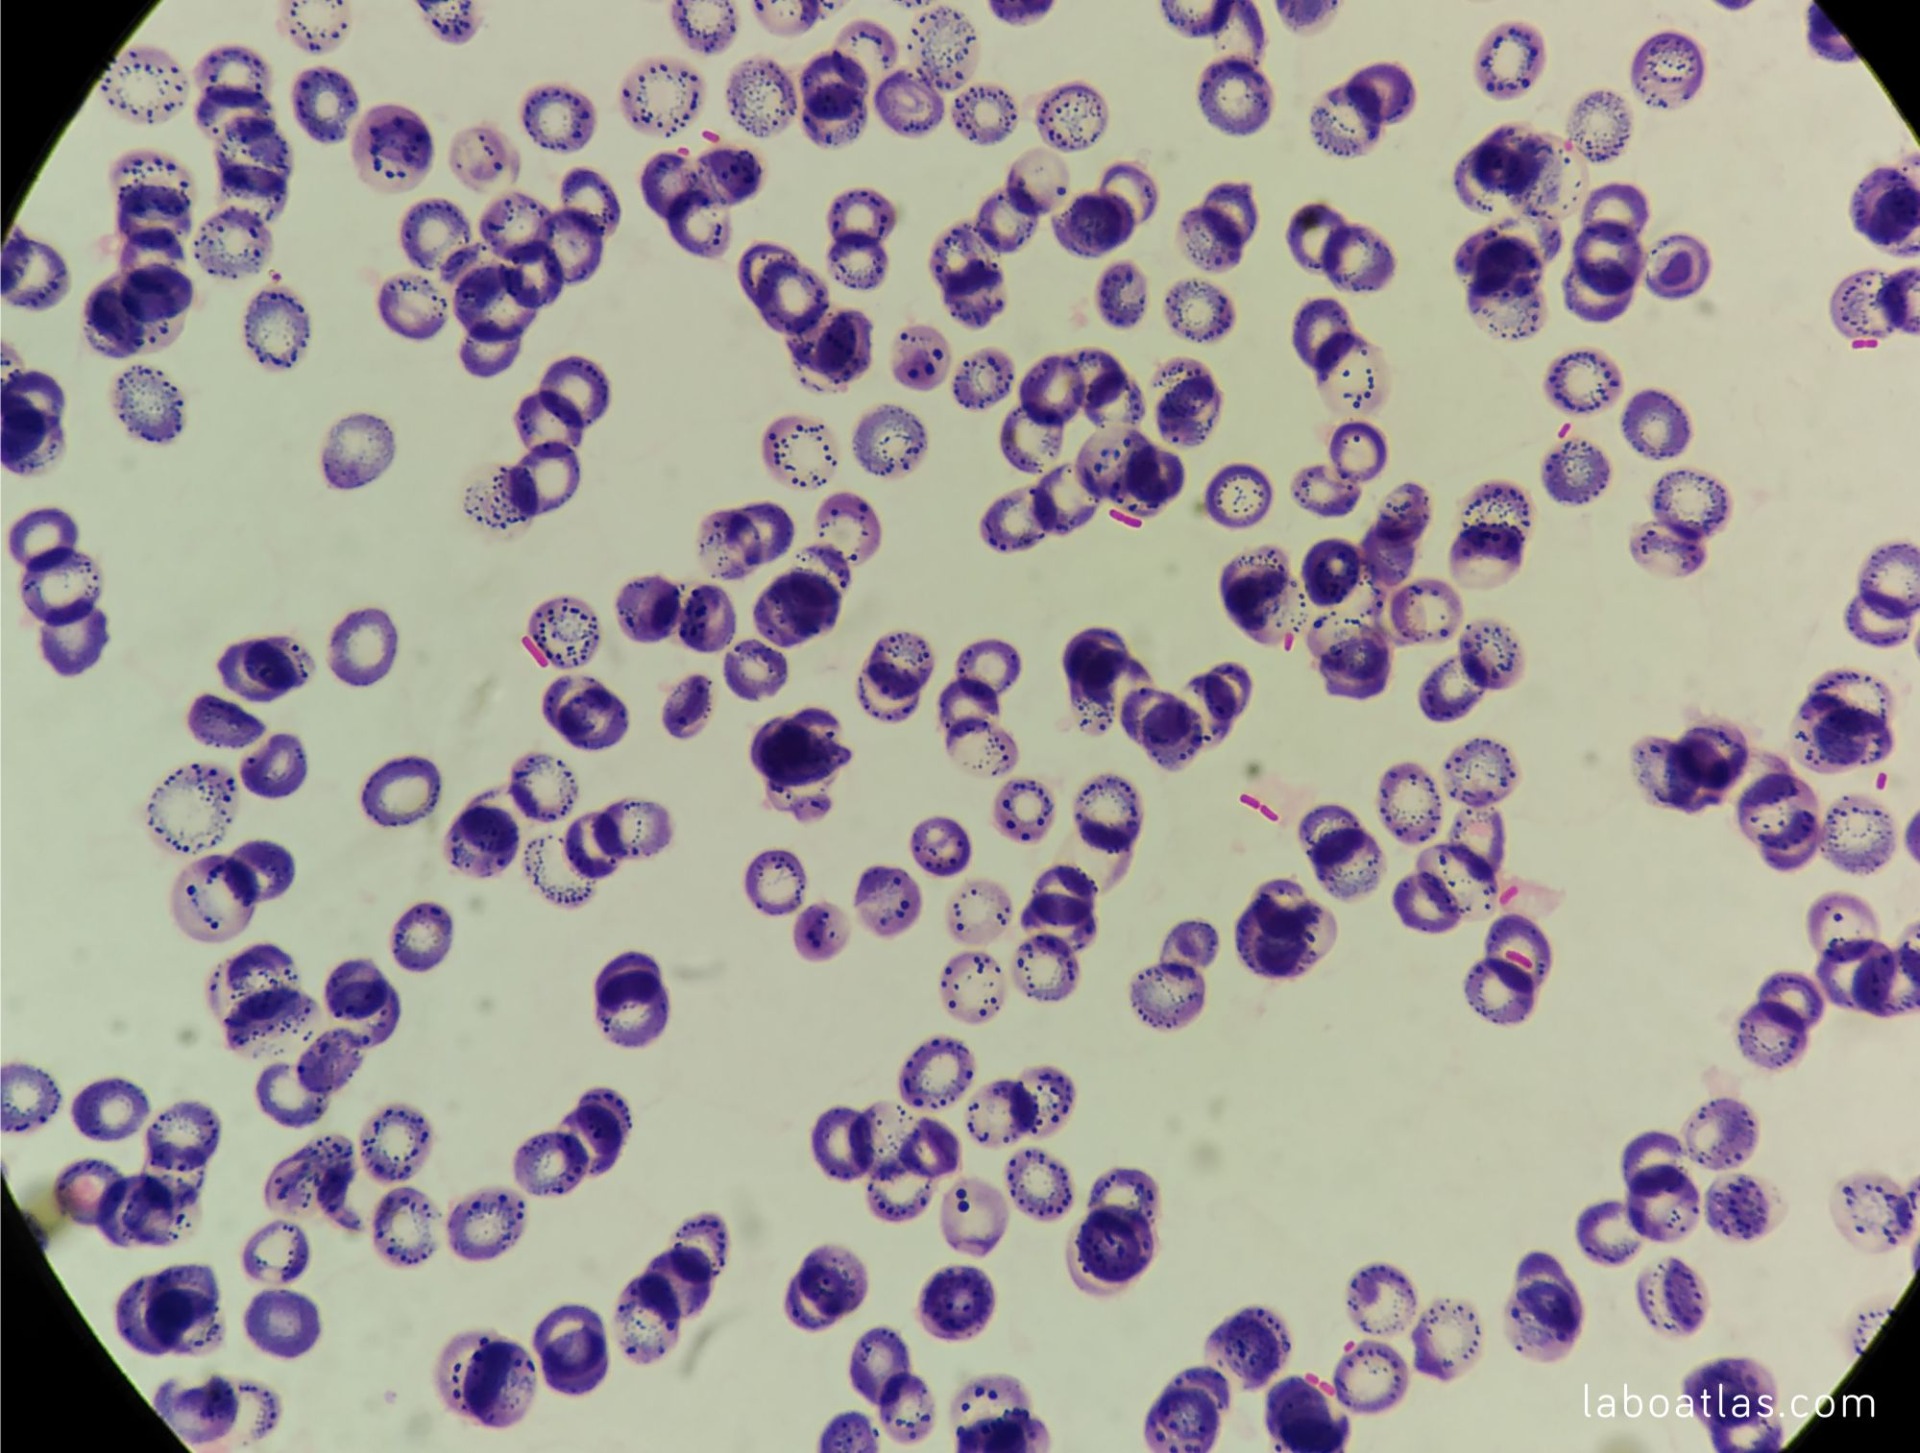

Práctica 3: Tinción de Gram
3/10/24
INTRODUCCIÓN:
La tinción de Gram es la tinción diferencial más utilizada en los laboratorios de microbiología. Tiene una gran importancia para la clasificación morfológica y taxonómica.
Se identifican dos grandes grupos, cuya diferencia radica en la composición química de la pared celular y su permeabilidad:
- Bacterias Gram negativas: Se tiñen de color rosáceo intenso o rojizo.
- Bacterias Gram positivas: Se tiñen de color azul violáceo.

OBJETIVOS:
- Diferenciar células Gram positivas y Gram negativas.
- Ver la morfología de las bacterias (cocos, bacilos) y su forma de agruparse.
- Aprender a realizar la tinción de Gram.
MATERIALES:
- 4 portaobjetos.
- 4 placas de Petri (con sus bacterias correspondientes).
- Un vaso de precipitados con agua destilada.
- Pipeta Pasteur.
- Tintes (cristal violeta, lugol, alcohol al 30% y fucsina al 5%).
- Mechero de alcohol.
- Asas de siembra desechables.
- Bacterias: Bacillus subtilis, Escherichia coli, Mycobacterium phlei, Staphylococos epidermis.
- Campana extractora (Botón FAN - luz ultravioleta (10-15 min) - luz de trabajo).
- Pinzas de madera.
- Cubeta de tinciones.
- Microscopio óptico.
- Rotulador permanente.
PROCEDIMIENTO:
1. En la campana se procede a coger una gota de agua destilada con una pipeta Pasteur y se coloca en el porta.
2. Se abre la placa de Petri y con un asa de siembra desechable se procede a recolectar varias bacterias.
3. Con el asa de siembra, se extiende en la gota de agua destilada del porta y se mezcla.
4. Se desecha el asa y se colocan unas pinzas de madera en el extremo.
5. Pasar el porta por la parte posterior a donde se encuentran las bacterias por encima de la llama de un mechero de alcohol hasta que se seque para fijar las bacterias al porta (Aquí hay que tener cuidado de no hacerlo pasar por el lado equivocado, ya que las muestras podrían perderse).
6. Colocar el porta en la cubeta de tinción.
7. Tintes:
Cristal violeta - 2 minutos.
Lugol - 1 minuto.
Alcohol al 30% - 30 segundos.
Fucsina al 5 % - 1 minuto.
Entre cada tinte hay que lavar con agua destilada para quitar el exceso.
8. Una vez teñido se deja secar al aire libre y se observa la muestra al microscopio.
En el siguiente vídeo se pueden observar los cinco primeros pasos, y en los últimos segundos se ve como se quita la fucsina con el agua destilada.

RESULTADOS:
Mycobacterium phlei (bacteria ácido-alcohol resistente, se tiñe con Ziehl-Neelsen).
Bacillus subtilis. Las fotos 1, 2 y 3 son al objetivo x100 con aceite de inmersión, la última es al x10/x40)
Staphylococos epidermis. Las dos primeras imágenes son con el objetivo de x40, y las dos últimas son al objetivo de x100 con aceite de inmersión.
De la Escherichia coli no se pudo hacer una foto porque no se veía nada al microscopio.
INTERPRETACIÓN DE LOS RESULTADOS:
Se ha obtenido un resultado negativo, ya que no se pudo ver ninguna Gram negativa (color rojizo) y solo se pudieron observar Gram positivas (color azulado). Se ha añadido una foto de cómo debería haberse visto la tinción. Debajo de esa foto sale como debería haberse visto la Escherichia coli al microscopio.

Asi se observaría con gram negativa: Asi se observaría con gram positiva:


